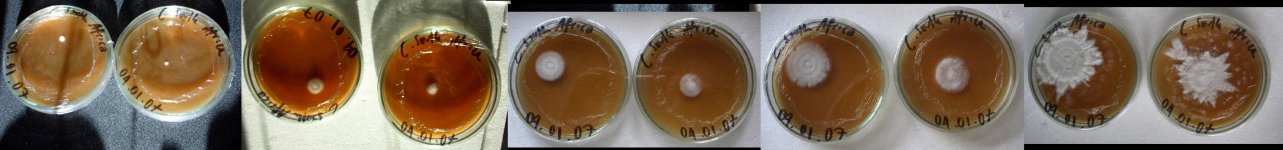
PCSA_Petri.jpg

Offtopic:
I used pasteurized vegetable soil.
Happy cultivation, tseuq
EternalPeace said:tseuq, what did you case that Mex A with? I'm eventually going to try to fruit my leftover truffle substrate.
I used pasteurized vegetable soil.
Happy cultivation, tseuq


 !
!